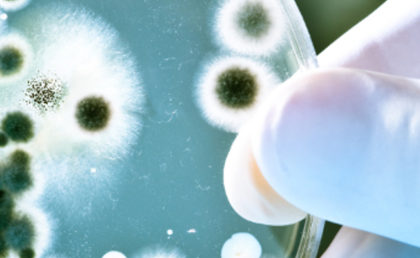
Koloniebildende Einheiten KBE Keimzahlen im Wasser

Als koloniebildende Einheit (KBE oder KbE, englisch colony forming unit, CFU) bezeichnet man einzelne oder mehrere zusammenhängende Individuen von Mikroorganismen, die durch ihre Vermehrung in oder auf einem Gel-Nährmedium eine Kolonie bilden. Diese Größe wird bei der Methode zur Quantifizierung lebender Mikroorganismen mit der Abkürzung KBE oder KbE bezeichnet.
Methode
Mikroorganismen können unter anderem mit kulturellen Methoden quantifiziert werden, z. B. durch einen Surface-viable Count oder einen Plaque-Assay. Dabei wird meistens eine Probe des Materials, dessen Mikroorganismengehalt bestimmt werden soll, auf der Oberfläche eines Kulturmedium-Gels oder im Kulturmedium-Gel möglichst gleichmäßig verteilt, so dass im Idealfall alle Individuen der Mikroorganismen einzeln und weit genug voneinander entfernt zu liegen kommen und bei geeigneten Kulturbedingungen durch Wachstum und Vermehrung jeweils eine mit dem Auge sichtbare Kolonie bilden. Die Anzahl der Kolonien ist unter diesen Idealbedingungen gleich der Anzahl der in der Probe enthaltenen Individuen. Tatsächlich aber können unter realen Bedingungen einige Individuen so dicht beieinander liegen, dass sie nur eine einzige gemeinsame Kolonie bilden, zudem haften oft einige Individuen so fest aneinander, dass sie nicht getrennt werden und sich ebenfalls nur eine Kolonie daraus entwickelt. Unter realen, nicht idealen Bedingungen ist also die Anzahl der Kolonien geringer als die Anzahl der in der Probe enthaltenen Individuen. Deshalb wurde der Begriff koloniebildende Einheit eingeführt, die sowohl einzelnen Individuen als auch mehreren aneinanderhaftenden oder dicht zusammen liegenden Individuen entspricht.
Eine Besonderheit der Methode, mit Hilfe einer Kultur und durch die Bestimmung der Anzahl koloniebildender Einheiten Mikroorganismen zu quantifizieren, ist, dass durch die Wahl der Kulturbedingungen (Kulturmedium, Temperatur, Sauerstoffverfügbarkeit und dergleichen) bei Mikroorganismen-Gesellschaften mit Arten, die verschiedene Ansprüche an die Kulturbedingungen stellen, oft nur eine Auswahl aller vorkommenden Mikroorganismen erfasst wird. Das kann vorteilhaft sein, wenn nur bestimmte physiologische Typen von Mikroorganismen erfasst werden sollen. Nachteilig ist das, wenn eine sogenannte Gesamtkeimzahl in einer gemischten Mikroorganismen-Gesellschaft bestimmt werden soll, also die Anzahl aller enthaltenen Mikroorganismen.
Siehe auch
- Keimgehalt
- Trinkwasserverordnung
- Wasseraufbereitung im Schwimmbad
Weblinks
Quellen
- Andreas Paetz: Wörterbuch Umweltuntersuchung: Begriffe, Definitionen und Erläuterungen aus den Bereichen Abfall, Boden, Wasser. Beuth Verlag, 2011, ISBN 3-410-17127-4, S. 157.